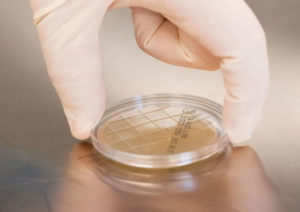
Surface-Sampling-for-ISO-Class-5-Primary-Engineering-Controls

Happy New Year – can you even believe that 2021 is almost behind us? As you know, at Berkshire we aim to bring you the very best of controlled environment news. Last year, we looked at copper and tobacco as allies in the fight against COVID-19 and took a leisurely break from viral problems to check out the retrieval of samples from Mars. This year, we’re getting smart with mushrooms, rediscovering wipers, gloving up to revisit the sanitary/unsanitary conundrum, and using those same gloved hands to applaud our very own Quality Team. So without more ado, let’s take a look at this year’s Top Ten!

1) Smart Fungus Among Us – Can Mushrooms Architect the Materials of the Future?
If you think that mushrooms are just a topping on your Friday night pizza, it’s time to think again! These days, fungi are architects and e-textiles, the daredevils of the construction industry and the darlings of bio-sensor technology. If this is news to you, take a look at our our #1 most popular article of 2021 here…

2) Isopropyl Alcohols – How Much Do You Really Know About the Mogul of the Cleanroom?
With great power comes…well, the need for great investigation. Isopropyl alcohols are amongst the most common consumables of the cleanroom or contamination-controlled environment. But how much do you know about these powerful solvents? If you need a brush up – and who doesn’t? – check out our #2 most read article of 2021…

3) The Science of Cleanroom Wiper Usage
Can we have your attention, please! Eh-hem….Did you know that there is a correct way to fold a wiper in order to maximize cleaning efficiency? And efficiency is not solely about ridding the cleanroom of pathogens: it’s also about cost – both to your organization and to the planet. But what is the correct procedure in wiper usage? Click here to read our #3 most popular step-by-step guide to cleanroom consumables…
4) Surface Sampling for ISO Class 5 Primary Engineering Controls
In pharmaceutical compounding, Primary Engineering Controls (PECs), also known as RODAC (Replicate Organism Detection and Counting) plates, are critical in the retrieval of microbial samples. But do you know what they’re made of, how to use them, or what they detect? If you’d like a refresher on surface sampling, look no further than our #4 top article of 2021…

5) Do Gloves Impact Your Work and Health?
Let’s face it, it’s been a long while since we’ve wanted to touch anything without the aid of sanitizer or gloves. But do gloves negatively impact our health? In our 5th most popular article, we discuss (amongst other things) ‘Sweaty Palm Syndrome,’ and ways in which you can combat it. Check out the article here…

6) Masks, Microbes, and Mushrooms – How Are You Protecting Against Fungi in the Cleanroom?
Yes, it is true that there can be fungus in the cleanroom. But, before you panic, let’s discuss ways of neutralizing it, using best practice guidelines to achieve maximum impact. Take a look at our #6 most read article for a refresher on the potential lethality of fungal contamination…

7) Congratulations Berkshire Quality Team
Way to go! If you know Berkshire, you know that we are committed to consistency and reliability in creating cleanroom supplies of exemplary quality. Our #1 priority is ensuring that you have the critical components you need to keep your business running smoothly. But who are the people driving this success? Get to know them in our #7 most frequently read article as you meet our Berkshire Quality Team…

8) Storage Protocols for SatPax® Presaturated IPA Wipes
If you need Safety Data Sheets, you can rely upon the fact that we have them! Especially if you are looking for the best ways to store and handle SatPax® pre-wetted wipers – in both nonwoven and knitted options. Different IPA saturation levels mean different handling, but we’ve got you covered in our #8 most accessed article – check it out here…

9) Revisiting the Unsanitary/Insanitary Conundrum of Custom Biopharmaceuticals
A perennial favorite, this article is critical if you want to understand the difference between sanitary and unsanitary. After all, we all know that transparency in terminology is especially important when public health is at stake, so why not take a refresher with our #9 most article of 2021…

10) What are Pyrogens and Endotoxins…and How Can They Be Controlled in a Cleanroom?
The terms bacterial endotoxin and pyrogen are often used interchangeably and refer to phospholipid-polysaccharides – also termed lipopolysaccharides, or LPS. If you are confused by these terms, it’s time to revisit our #10 most popular article of 2021 and get up to speed with pyrogens, endotoxins, and so much more…








HAVE AN IDEA FOR CONTENT?
We are always looking for ideas and topics to write about.
Contact Us